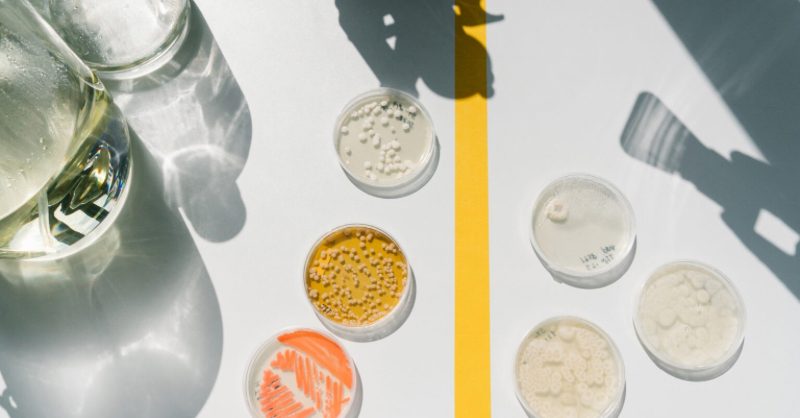

SMEY launches Lipid Atlas to transform lipidomics research
French-German biotech company SMEY has announced the launch of Lipid Atlas, an AI-driven platform designed to accelerate and standardise advanced lipidomics research. The new solution targets pharmaceutical companies, academic labs and clinical researchers seeking deeper insights into lipid profiles and their role in disease.
AI-powered engine for complex lipid data
Lipid Atlas combines high-throughput analytical workflows with proprietary AI algorithms capable of processing large-scale mass spectrometry datasets. By automating peak detection, annotation and classification of lipid species, the platform aims to reduce analysis time from weeks to hours while improving reproducibility and data quality.
According to SMEY, the system integrates curated reference libraries, advanced pattern recognition and predictive modelling to help scientists identify novel biomarkers, map lipid pathways and explore disease mechanisms in areas such as metabolic disorders, cardiovascular disease and neurodegeneration.
Supporting precision medicine and drug discovery
The company positions Lipid Atlas as a critical tool for next-generation precision medicine. By enabling more detailed lipid profiling in patient samples, the platform can support stratification of patient cohorts, monitoring of treatment response and early detection of therapy-induced toxicities.
For the pharmaceutical sector, Lipid Atlas is intended to streamline drug discovery workflows. Automated analysis and integrated visualisation tools allow R&D teams to correlate lipid signatures with target engagement, mechanism of action and efficacy, potentially shortening development timelines and reducing experimental costs.
Cloud-native, collaborative infrastructure
The platform is delivered as a secure, cloud-based service, offering scalable storage and compute capacity for multi-site research programmes. Role-based access, audit trails and integrated data-sharing features are designed to support collaborations between hospitals, universities and industry partners while complying with strict data governance requirements.
With the launch of Lipid Atlas, SMEY strengthens its position in the European biotech ecosystem, betting that AI-enhanced lipidomics will become a core component of systems biology, clinical research and personalised healthcare strategies worldwide.